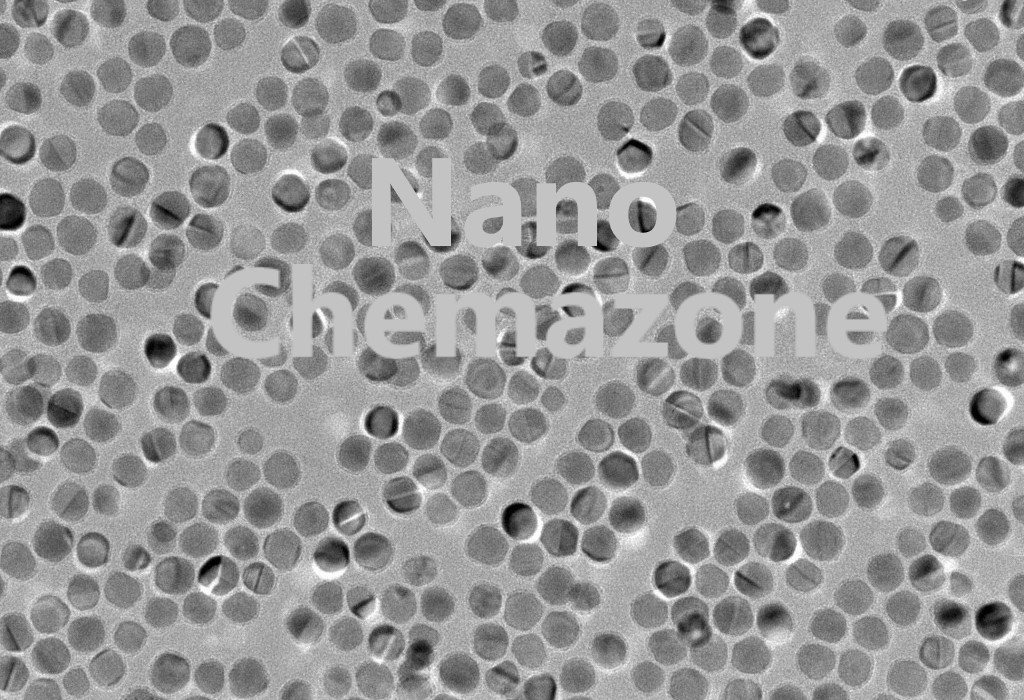

Note: For pricing & ordering information, please contact us at info@chemazone.in
Please contact us for quotes on Larger Quantities & Customization. E-mail: info@chemazone.in
Customization:
If you are planning to order large quantities for your industrial and academic needs, please note that customization of parameters (such as size, length, purity, functionalities, etc.) are available upon request.